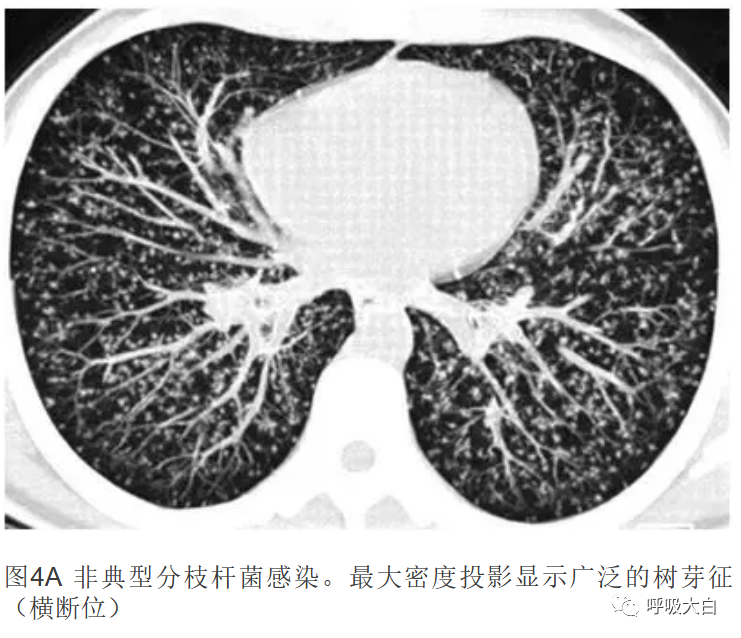
图片

在影像科医生对疾病诊断中,捕捉征象非常重要,特别是一些典型的征象往往能起到缩小鉴别诊断范围的作用,有些甚至可以直接做出明确诊断。在肺部 CT 的影像学检查中,树芽征就是这样一种影像学征象。树芽征病变累及细支气管以下的小气道,由于小叶中心性的气道扩张和管腔内粘液、脓液等炎性物质的填充,在肺部薄层 CT 或 HRCT 上表现为直径 2~4 mm 的小叶中心软组织密度结节影和与之相连的分支线状影,形似春天里树枝发芽的征象。
肺小叶内的细支气管在正常情况下是无法辨别的,但当细支气管阻塞扩张,细支气管管壁增厚,管周浸润,细支气管管腔被粘液、脓液、流体或癌栓浸润等情况下,薄层 CT 或高分辨 CT 即可呈现为树芽状。小气道树形分支状结构是树芽征形成的解剖学基础。树芽征中的「树」和「芽」分别代表着不同意义。「树」指的是因阻塞而扩张的细支气管,「芽」指的是呼吸性细支气管和肺泡管内充的粘液等物质。![图片]() 树芽征示意图
树芽征示意图
树芽征是由多种影响小气道的病变所引起的一种非特异征象,它的出现多提示小气道炎症病变,多种疾病可表现为树芽征。如下表所示:(注:参照李贺等人文章及 2005 年 Radiographics 综述)树芽征起初用于描述结核的支气管播散,这是HRCT能准确诊断结核活动的唯一依据。如怀疑为肺结核并支气管播散,可以去找可诊断结核的其他线索:病变是否为多形态(渗出、增殖、纤维化、钙化)、多病灶、多叶分布、典型的好发部位(上叶尖后段、下叶背段)、肺门和纵隔淋巴结是否有典型的环状增强,临床上是否有结核的全身中毒症状。相关辅助检查:痰涂片抗酸染色、PPD、结核抗体等,如痰涂片未找到结核杆菌,如满足菌阴肺结核诊断标准,即可诊断为肺结核。经抗结核治疗后,这些病变均可吸收。所以胸部CT如发现树芽征,应高度警惕有无肺结核可能。![图片]()
肺结核的树芽征树芽征的典型病因是原发后结核(图 3A,3B),约5%的原发性肺结核患者会发展为原发后结核,并常伴有营养不良和免疫低下。有时,它反映再感染新的病原体。树芽征提示疾病活动和播散,尤其在肺内合并有空洞时。最常见的CT表现是小叶中心结节和分支样线状影和结节影。这时树芽征是由于终末支气管、呼吸性细支气管及肺泡管内和周围出现干酪样坏死和肉芽肿性炎症,反映出结核沿支气管腔播散。其他常见的影像表现有空洞性结节,肺叶实变,叶间隔增厚,和支气管血管变形。可见由干酪样坏死导致的胸膜渗出和淋巴结肿大伴中央低密度。在抗结核治疗开始后,多数小叶中心结节和分支样不透明影在5个月内吸收消失。但是在随访CT中,支气管血管变形,纤维化,肺气肿,和支气管扩张增多。虽然非典型分支杆菌不好发于上叶,但其产生的病变形式可能与肺结核的表现无差异 (图 4A,4B)。这种情况在鸟型分枝杆菌感染或鸟型分支杆菌复合体感染中也可见,尤其是HIV感染并免疫功能缺陷患者。金黄色葡萄球菌感染和流感嗜血杆菌所致的细支气管炎也可出现类似的肺外周树芽征。2.其他感染:金黄色葡萄球菌、流感嗜血杆菌、真菌、病毒、寄生虫除了结核杆菌感染可导致树芽征外,金黄色葡萄球菌、流感嗜血杆菌、气道侵袭性曲菌病、病毒等感染也可以树芽征为主要表现,所以,树芽征、发热,考虑感染性可能性大,但不能只盯着结核病看,应进一步结合临床表现及实验室检查考虑有无其他感染的可能性。侵袭性气道曲霉菌引起的细支气管炎最常见于中性粒细胞减少和免疫缺陷患者(如AIDS)。气道腔内常可发现菌丝。这种疾病的其他临床表现是支气管肺炎(沿支气管周围分布的实变)和气管支气管炎(支气管扩张,以及气管或支气管壁增厚),通常在双侧。在白血病患者中,如果出现树芽征并有实变,伴有磨玻璃影晕征,应该提示侵袭性气道曲霉病。免疫缺陷患者常发生巨细胞病毒感染,可引起细支气管炎伴有小叶中心结节及支气管血管束增厚,表现为树芽征。病变可表现为斑片状,单侧或双侧不对称分布,可进展为磨玻璃影和实变。也可出现边界不清的结节,CT上呈晕圈征。在婴儿和幼儿中,树芽征最常见于合胞体病毒感染所致的支气管壁增厚和扩张。案例一 基本病史:男,15 岁,伴有急性呼吸道感染症状 胸部 CT 平扫显示双肺弥漫性高密度病灶,胸膜下病变多呈树芽征改变 案例二 基本病史:男性,60 岁,伴有慢性支气管炎和支气管扩张病史。 肺部 CT 平扫显示胸膜下支气管扩张梗阻,呈树芽征。余可见支气管扩张双规征 案例三 基本病史:女性,66 岁,伴有慢性咳嗽病史。![图片]() 肺部 CT 平扫发现右肺下叶多发小叶中心性结节与扩张梗阻的细支气管相连(箭头所示),呈树芽征。该患者最终诊断为继发性肺结核 案例四 基本病史:男,17 岁,伴有慢性咳嗽病史。胸部 CT 显示多发扩张厚壁支气管及胸膜下树芽征,最终诊断囊性肺纤维化案例五 基本病史:31 岁男性,既往有腹部促纤维增生性小圆细胞肿瘤病史。胸部 CT 显示多发扩张呈串珠样改变的肺动脉(A)和树芽征(箭头所示),病变最终诊断为肺外恶性肿瘤栓子浸润所致(摘自 AJR 杂志)总结:树芽征是肺部病变常见的征象,多可提示炎症的存在,但并非特异性征象,可见于多种不同的疾病。了解树芽征的病理机制,形成原因,常见疾病对于预防误诊具有重要作用。
肺部 CT 平扫发现右肺下叶多发小叶中心性结节与扩张梗阻的细支气管相连(箭头所示),呈树芽征。该患者最终诊断为继发性肺结核 案例四 基本病史:男,17 岁,伴有慢性咳嗽病史。胸部 CT 显示多发扩张厚壁支气管及胸膜下树芽征,最终诊断囊性肺纤维化案例五 基本病史:31 岁男性,既往有腹部促纤维增生性小圆细胞肿瘤病史。胸部 CT 显示多发扩张呈串珠样改变的肺动脉(A)和树芽征(箭头所示),病变最终诊断为肺外恶性肿瘤栓子浸润所致(摘自 AJR 杂志)总结:树芽征是肺部病变常见的征象,多可提示炎症的存在,但并非特异性征象,可见于多种不同的疾病。了解树芽征的病理机制,形成原因,常见疾病对于预防误诊具有重要作用。

 树芽征示意图
树芽征示意图

肺部 CT 平扫发现右肺下叶多发小叶中心性结节与扩张梗阻的细支气管相连(箭头所示),呈树芽征。该患者最终诊断为继发性肺结核
肺部 CT 平扫发现右肺下叶多发小叶中心性结节与扩张梗阻的细支气管相连(箭头所示),呈树芽征。该患者最终诊断为继发性肺结核 
